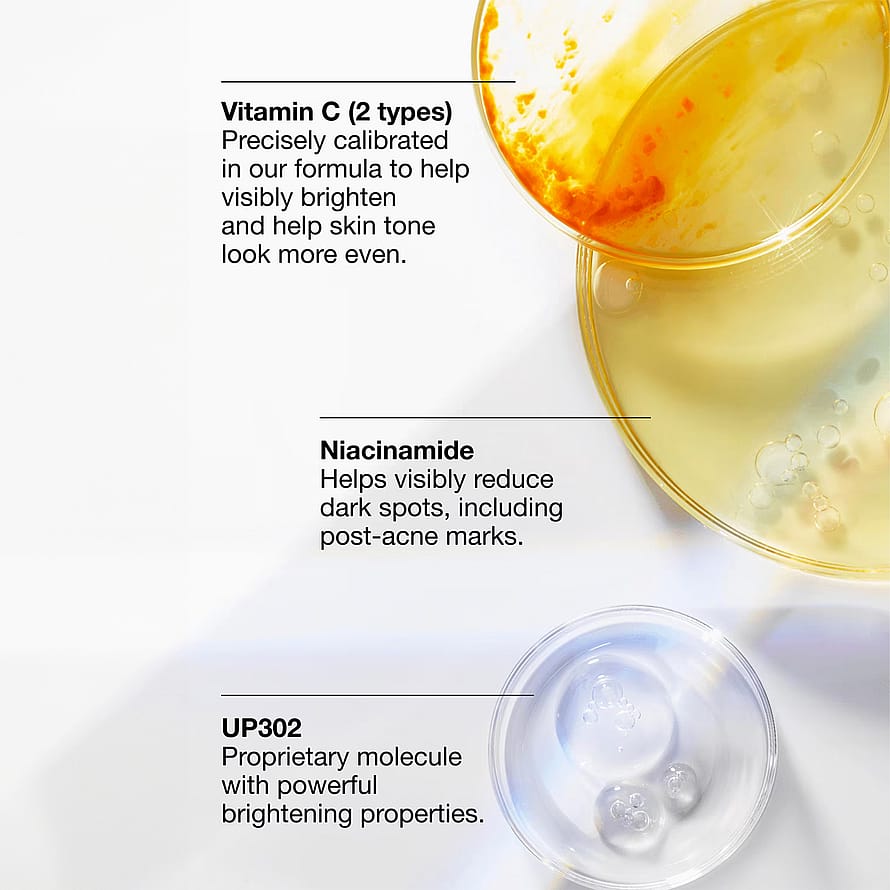

1 / 1

- Vill du titta på videon?Då behöver vi att du accepterar funktionella cookies
Even Better Dark Spot Clearing Serum
Storlek:30 ml
Pris: 879 kr
Med denna produkt får du fri leverans ·
| Innehåll | 30 ml |
| Enhetspris | 29 300 kr/l |
| Varumärken | Clinique |
| Kategori | Återfuktande Serum |
| Visa allt | Clinique Återfuktande Serum |
| Artikelnummer | 1023112 |
| EAN | 192333166925 |
Du kan betala med valfri metod hos oss. Du väljer betalningsmetod i kassan.
- Visa
- Mastercard
- Swish
- Klarna
Vill du se innehållet?
Då behöver vi att du accepterar funktionella cookiesInspiration

Kundrecensioner
Bli först med att recensera denna produkt
Alla recensioner läses av KICKS kundservice innan publicering. Läs mer